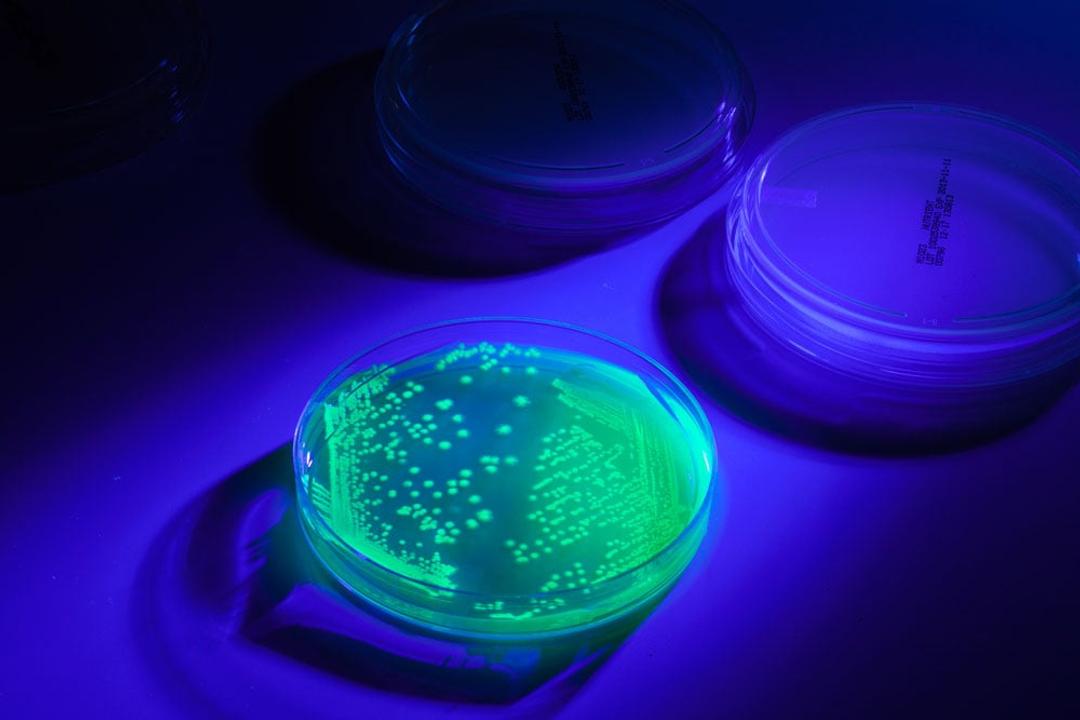

UV-BioTAG - Escherichia coli (O157:H7) EC43 Derived from FDA ESC1177 (STEC)
UV-BioTAG - The next phenomenon: QC microorganisms with Green Fluorescent Protein (GFP) markers

The supplier does not provide quotations for this product through SelectScience. You can search for similar products in our Product Directory.
It’s not uncommon for food samples to inadvertently become contaminated with control strains used in the laboratory. This leads to false-positive results which can have severe financial and regulatory implications. UV-BioTAG, our line of reference strains containing green fluorescent protein (GFP) markers, makes is easy to distinguish natural contaminants from laboratory control strains. Optimized for highly visible fluorescence, UV-BioTAG strains provide better stability because the GFP marker is integrated into the chromosome rather than the plasmid. With UV-BioTAG, you can quickly and reliably establish whether a positive test result can be traced back to a control strain cross-contamination issue, or if it is from another source.
- Serotype O157:H7
- GFPUV
- Cm10R
- Kits include six swabs each containing one lyophilized pellet of an individual microorganism strain
- Fluoresces under UV light to distinguish QC strains from other possible contaminants
- Instant dissolve pellet reduces preparation time
- Ready-to-use format saves time and money
- Refrigerated storage is easy and economical
- Online Certificate of Analysis provides detailed strain information
- Traceability to reference cultures ensures authenticity
- Technical Support experts available for guidance
- Product warranty